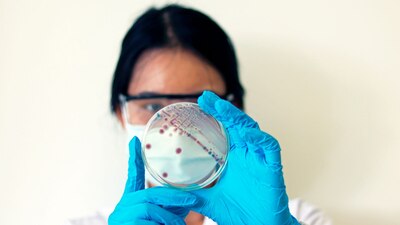
alt default

La bacteria vibrio vulnificus, también conocida como la ‘bacteria come carne’, ha cobrado a vida de al menos ocho personas en Florida y Louisiana, en Estados unidos, así lo informaron los Departamentos de Salud de ambos estados.
Las autoridades sanitarias indicaron que otras 22 se han contagiado con el microorganismo, por lo que señalan este hecho como un brote infeccioso inusualmente alto.
Hasta el momento en Florida se han registrado 13 infecciones y cuatro muertes, con fallecimientos aislados en los condados de Bay y Hillsborough en la Costa del Golfo de México, pero también los condados con costa atlántica de St. Johns y Broward.
En tanto, el Departamento de Salud de Louisiana emitió una alerta la semana pasada indicando que en lo que va del año se han registrado 17 casos de vibrio vulnificus en ese estado.
¿QUÉ ES LA BACTERIA ‘COMECARNE’?
La bacteria Vibrio vulnificus suele prosperar en ambientes de agua salada cálida y en zonas de aguas salobres, donde confluyen el agua dulce y la salada, así lo explicó el doctor Alok Patel, colaborador médico de ABC News y pediatra en Stanford Children’s Health.
“Esta bacteria normalmente existe en aguas cálidas y saladas, a veces en aguas salobres, especialmente durante los meses de verano”, señaló el especialista.
Subrayó que la vía de transmisión principal ocurre por la exposición de heridas abiertas al agua costera infectada o por el consumo de mariscos crudos o poco cocidos, en particular ostras.